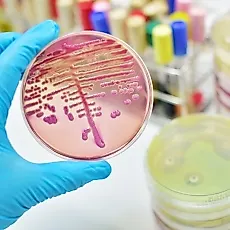
Инфекционные заболевания

Материалы по метке "организм"
Препараты

GenF20 Plus

ProShape RX

Мегавитамины

Иммунобустер - СoreNRG

Detox Pro.Active

Прелюзель

Оптимер

Флавопримум

Формула 3

Органический цинк
Страницы

Вред или польза?
За 20 лет существования на российском рынке биологически активные добавки обрели у нас в стране своих горячих поклонников

Рецепт молодости
Рецепт молодости. Хотите выглядеть молодо даже в зрелом возрасте?
Новитал -секрет молодости
Омоложение. Гормон роста

Состав гормона роста
Состав бад Новитал - стимулятора гормона роста
Ответы на вопросы о Новитал
Вопросы и ответы про биологически активная пищевая добавка Новитал.

Методы омоложения
Эфирные масла против старения. Омоложение организма

Климакс. Менопауза
Климакс период в жизни характеризующийся угасанием половой функции женщины, связанной с возрастными изменениями в организме

Фитотерапия
Фитотерапия , являются щедрым даром самой природы, несущим в себе естественную силу целебных трав в концентрированном виде

Остановить старение
Остановить старение можно ! Уникальный эффект омоложения от приема гормона роста

Ожирение и питание
Ожирение и его профилактика, здоровое питание, как правильно считать калории

Антиоксиданты
Важнейшие вещества для борьбы со свободными радикалами, могут замедлить или предотвратить окисление органических соединений.

Характеристики витаминов
Витамины – это вещества, которые необходимы для нормального функционирования всех систем человеческого организма. Витамины играют наиважнейшую роль в жизни человека.
Флавопримум
Флавопримум - антиоксидантный препарат немедленного действия
Флавопримум - новый шаг в развитии антиоксидантов
Флавопримум - новый шаг в разработке современных антиоксидантных препаратов

Гормон роста человека
Гормон роста человека (ГРЧ, HGH, Соматропин, Соматотропин, Somatropin) HGH (Human growth hormone) или гормон роста человека считается "ключевым" гормоном

Витамины для ...
Роль витаминов в питании человека – это обеспечение нормального функционирования всех внутренних органов и систем организма

Свободные радикалы
Свободный радикал - это атом или группа атомов, которые содержат по крайней мере один непарный электрон.

Как убрать живот
Как убрать жир с живота? 90% взрослого населения планеты совершенно недовольны своей фигурой

Токсемия
Токсинемия — отравление организма, вызванное наличием в крови токсинов, поступающих извне или образующихся в самом организме

Микроэлементы
Микроэлементы – это «пища главным образом для желез внутренней секреции», для ферментов (энзимов)
Инфекционные заболевания
Инфекционные заболевания — группа заболеваний, вызываемых проникновением в организм патогенных (болезнетворных) микроорганизмов, вирусов и прионов.
Статьи
О тайнах Азота
Живая вода молодильные яблоки, чудодейственные травы
О «жизненной силе»
Почки у женщины от природы обладают запасом «жизненной силы»
Убрать жир с живота
Медики считают, что убирать жир с живота просто необходимо, так как он более опасен, чем подкожный жир на бедрах.
Витамин К
Витамин К — жирорастворимый витамин, состоящий из кольца нафтохинона и алифатической боковой цепи.
Витамин С
Витамин С относится к группе водорастворимых витаминов, он не может накапливаться в организме
Витамин B5
Витамин B5 содержится в зерновых продуктах, хлебных и пивных дрожжах, а также в некоторых овощах.
Апельсин
Апельсин ценен за большое количество аскорбиновой кислоты.
Черная смородина
Смородина черная (поричка, домашний доктор, подагровая ягода, альпийская ягода)
Сахар, сладости
Рак молочной железы, склероз и инфаркт связаны со слишком большим употреблением жира, сахара и сладостей
Лекарства, табак, алкоголь
Лекарства, табак, алкоголь – сильнодействующие яды.
Соль
Столовая, или кухонная, соль – единственная минеральная соль, которую каждый человек регулярно добавляет в пищу
Слизистая пища
Как предупредить и устранить накопление слизи в организме?
Соли кальция
Соли кальция – основной строительный материал костей, зубов, ногтей; они также необходимы и для мышц
Магний
Человек не может быть здоровым, если в его пище недостает солей магния. Ионы магния.
Цинк
Пять тысяч лет назад египтяне пользовались цинковой мазью для быстрого заживления ран.
Железо
Железо участвует в процессах кроветворения, создании гемоглобина